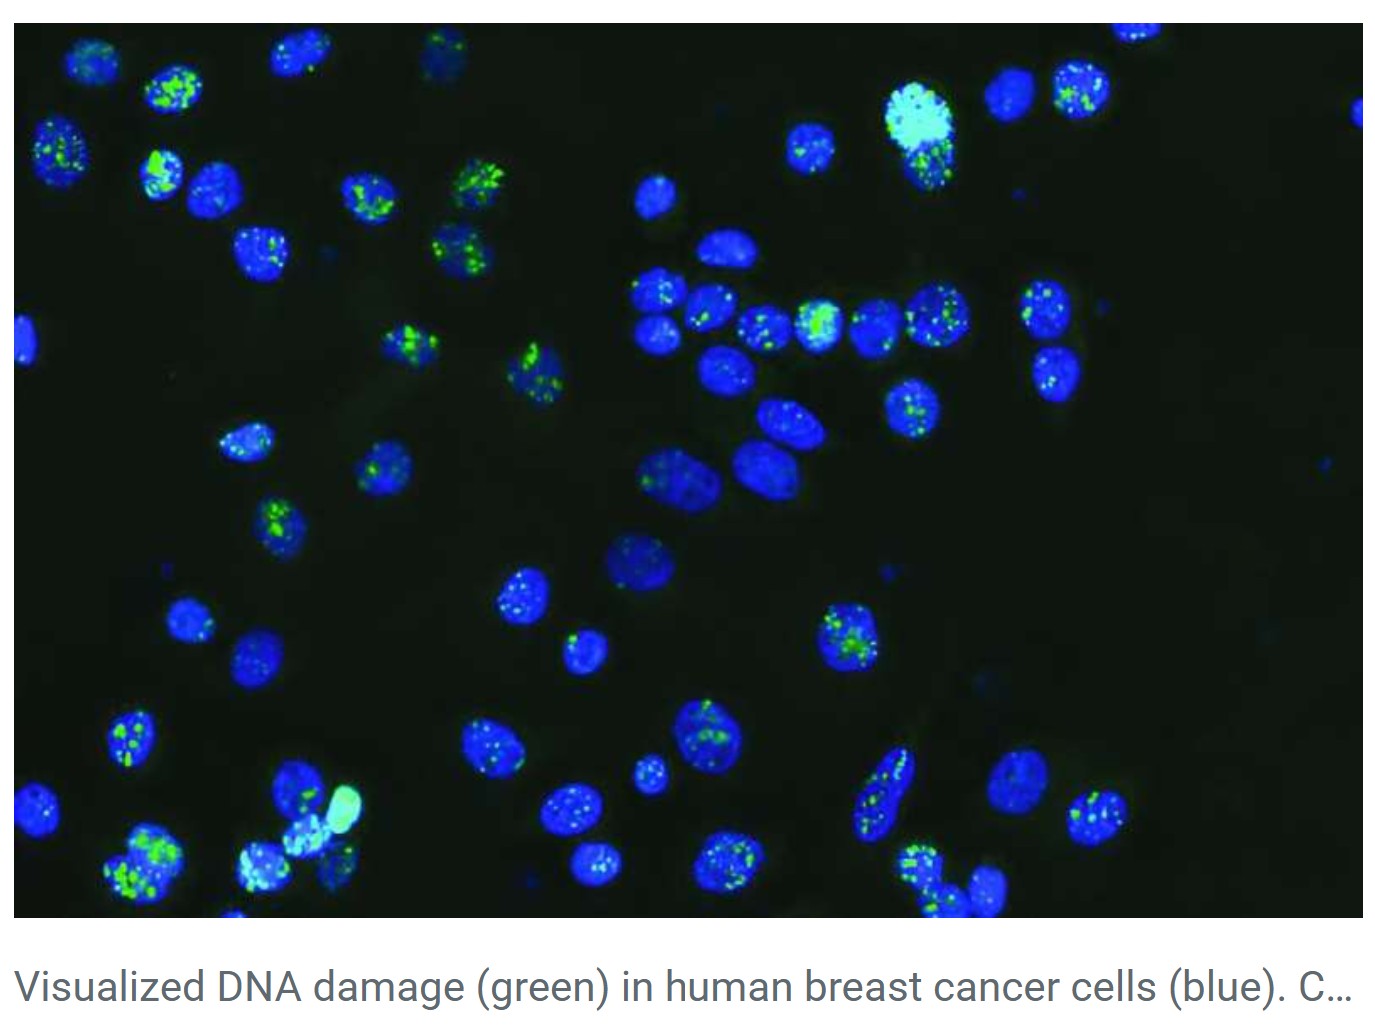

Junk DNA
- 10 Nov 2025
In News:
For decades, large portions of the human genome were dismissed as “junk DNA”- genetic material assumed to have little or no functional value. However, advances in genetics, genomics, and artificial intelligence are rapidly reshaping this understanding. Recent research, particularly the discovery of cancer-linked mutations in non-coding DNA, highlights how so-called junk DNA plays a crucial role in gene regulation, genome architecture, evolution, and disease.
Understanding Junk DNA
In genetics, junk DNA refers to regions of DNA that do not code for proteins. While DNA’s primary role is to provide instructions for protein synthesis, not all DNA sequences serve this function.
- In the human genome, nearly 98% of DNA is non-coding, whereas in simpler organisms like bacteria, only about 2% of DNA is non-coding.
- A part of non-coding DNA is known to have clear functions, such as producing:
- Transfer RNA (tRNA)
- Ribosomal RNA (rRNA)
- Regulatory RNAs
- However, a substantial fraction neither codes for proteins nor produces RNA, and its function remained unclear- hence the term junk DNA.
Over time, scientists have accumulated evidence that these regions are not entirely useless. Some DNA fragments that were originally non-functional have acquired functions through exaptation—a process by which structures or sequences evolve new roles not originally shaped by natural selection.
Emerging Functional Significance of Non-Coding DNA
Modern genomics has revealed that non-coding DNA plays a vital role in:
- Gene regulation (switching genes on or off),
- Chromatin organisation,
- Genome stability,
- Evolutionary innovation.
These roles become especially critical in understanding complex diseases such as cancer, where gene regulation and genome structure are often disrupted.
Breakthrough Discovery: Cancer Mutations in ‘Junk’ DNA
A recent study by the Garvan Institute of Medical Research, published in Nucleic Acids Research, marks a major breakthrough. Using artificial intelligence and machine learning, researchers identified a new class of cancer-driving mutations hidden in non-coding DNA.
Key Findings
- Mutations were found in non-coding regions across at least 12 cancer types, including breast, prostate, and colorectal cancers.
- Every tumour sample analysed had at least one mutation in these critical non-coding regions.
- These mutations were located at specific DNA sites that bind a protein called CTCF (CCCTC-binding factor).
Role of CTCF and Genome Architecture
CTCF is a key protein that helps fold long strands of DNA into precise three-dimensional (3D) structures inside the nucleus. These structures act as genomic “anchors”, bringing distant DNA regions together and controlling which genes are expressed.
- Some CTCF binding sites are “persistent anchors”, meaning they are present across many cell types.
- Mutations at these sites disrupt the 3D organisation of the genome, leading to abnormal gene activation or suppression.
- Such disruptions give cancer cells a survival and growth advantage, turning these sites into mutational hotspots.
To identify these sites, researchers developed an AI-based tool called CTCF-INSITE, which analysed genomic and epigenomic data from over 3,000 tumour samples using data from the International Genome Consortium.
Implications for Cancer Diagnosis and Treatment
This discovery has far-reaching implications:
- Universal cancer targets: Since the same non-coding mutations appear across multiple cancers, therapies could potentially work across cancer types rather than being mutation-specific.
- Early diagnosis: Alterations in these genomic anchors could serve as biomarkers for early cancer detection.
- New treatment strategies: Researchers plan to use CRISPR gene-editing to study how correcting these mutations affects cancer progression.
- AI in healthcare: The study demonstrates how artificial intelligence can uncover hidden patterns in vast biological data sets.
GPS Spoofing

- 10 Nov 2025
In News:
The recent disruption of flight operations at Indira Gandhi International (IGI) Airport, Delhi, due to GPS spoofing, has brought renewed attention to emerging non-traditional threats to civil aviation. Though commonly associated with conflict zones and electronic warfare environments, this incident highlights how cyber–electromagnetic threats can spill over into civilian airspace, raising serious concerns for aviation safety, national security, and technological resilience.
What is Spoofing and GPS Spoofing?
A spoofing attack is a category of cyberattack in which false data is masqueraded as coming from a trusted source to deceive systems or users. Common forms include:
- GPS spoofing
- IP spoofing (often linked with DDoS attacks)
- SMS and Caller ID spoofing
GPS spoofing specifically involves the broadcast of counterfeit satellite navigation signals that imitate genuine Global Positioning System (GPS) signals. Unlike GPS jamming, which simply blocks or degrades signals, spoofing is more dangerous because it feeds incorrect but believable navigation data to receivers.
Since real GPS satellite signals are extremely weak when they reach Earth, a receiver may mistakenly prioritise stronger fake signals, calculating incorrect position, altitude, speed, and timing. The ultimate objective is to induce the target—such as an aircraft—to act on false navigation information.
The IGI Airport Incident: What Happened?
At IGI Airport, spoofed GPS signals corrupted aircraft navigation systems, particularly affecting flights approaching Runway 10/28, a key runway heavily used during winter operations. The spoofing interfered with the Required Navigation Performance (RNP) system, which is a satellite-based precision landing mechanism.
As a result:
- Pilots received incorrect positional data during approach.
- Precision landings using GPS became unreliable.
- Several flights, including those of Air India and Vistara, were diverted.
- Air traffic congestion increased, especially during easterly wind conditions when alternative runways were constrained.
This marked the first known GPS spoofing incident in Delhi’s civilian airspace, making it unusual, as such attacks are typically reported in active conflict or military zones.
Response by Aviation Authorities
Delhi International Airport Ltd (DIAL) and aviation authorities responded swiftly:
- Cautionary alerts were issued to pilots via the ATIS (Airport Terminal Information System).
- Airlines were advised to temporarily suspend RNP-based landings.
- Aircraft were instructed to rely on ground-based navigation aids such as:
- ILS (Instrument Landing System)
- VOR (VHF Omnidirectional Range)
- Visual approach procedures
- The installation and commissioning of a new ILS for Runway 10/28 was expedited, with validation trials conducted by airlines like IndiGo.
Indian pilots’ training in fallback navigation methods played a critical role in preventing accidents.
Why GPS Spoofing is Dangerous for Aviation
GPS spoofing poses serious safety risks, especially in civil aviation:
- Incorrect altitude and position data can compromise approach and landing.
- Sudden false deviations may prompt dangerous corrective manoeuvres.
- Errors in timing can affect autopilot systems, collision avoidance, and air traffic coordination.
- Over-reliance on satellite navigation without redundancy can increase vulnerability.
Globally, the threat is rising. According to the International Air Transport Association (IATA), there were over 4.3 lakh incidents of GPS jamming or spoofing in 2024, a 62% increase compared to 2023, mostly over conflict-prone regions.
Global and Geopolitical Dimension
GPS spoofing is frequently reported in:
- Black Sea region
- West Asia and the Middle East
- Active military or electronic warfare zones
Experts believe the Delhi incident may have been caused by spillover of electronic warfare activities from conflict zones in West Asia. Under certain atmospheric conditions, distorted or spoofed signals can travel up to 2,500 km, affecting regions far removed from the actual source. Similar disruptions have previously impacted civilian flights over Turkey, Russia, and Ukraine.
This underlines a critical reality: modern warfare technologies can have unintended transnational consequences, blurring the line between military and civilian domains.
UN Water Convention

- 10 Nov 2025
In News:
- Bangladesh became the first country in South Asia to accede to the UN Water Convention.
- Move highlights growing importance of transboundary water governance amid climate change and upstream interventions.
UN Water Convention
- Official Name: Convention on the Protection and Use of Transboundary Watercourses and International Lakes
- Adopted: 1992 (Helsinki)
- Entered into force: 1996
- Serviced by: United Nations Economic Commission for Europe (UNECE)
- Original scope: Pan-European region
- Global access: Open to all UN Member States since March 2016
Core Features of the Convention
- Legally binding international framework
- Promotes:
- Equitable and reasonable utilisation of shared watercourses
- Prevention, control, and reduction of transboundary impacts
- Sustainable management of international rivers and lakes
- Mandates:
- Cooperation among riparian states
- Formation of joint bodies and basin-level agreements
- Does not replace bilateral/multilateral treaties; rather supports and strengthens them
- Instrument for achieving SDGs, especially:
- SDG 6 (Clean Water and Sanitation)
- SDG 16 (Peace and Institutions)
- SDG 17 (Partnerships)
Why Bangladesh Joined – Key Drivers
- Downstream dependency:
- Shares the Ganges–Brahmaputra–Meghna (GBM) basin with India and China
- Only ~7% of GBM watershed lies within Bangladesh
- Water stress indicators:
- 60% population vulnerable to floods
- 20–25% land flooded annually
- 81 of 1,415 rivers dried up or near extinction
- Salinity intrusion and sea-level rise in delta regions
- Climate change impacts:Altered Himalayan River flows
- Legal step:
- Bangladesh High Court (2019) declared rivers as “legal persons”
Regional Context
- China:Motuo Hydropower Station on Yarlung Tsangpo (Tibet) – world’s largest proposed dam
- India:
- Existing treaties:
- Indus Waters Treaty (1960) – Pakistan
- Ganges Water Treaty (1996) – Bangladesh (renewal due 2026)
- Disputes:
- Teesta River
- Tipaimukh Dam (Barak River)
- River interlinking concerns
- Existing treaties:
India’s Concerns
- Convention may:
- Strengthen Bangladesh’s negotiation position
- Influence future Ganges Treaty renegotiation
- India traditionally prefers bilateral mechanisms over multilateral water frameworks
- Possibility of:
- Nepal & Bhutan following Bangladesh
- Bangladesh exploring trilateral cooperation with China and Pakistan
Black-Headed Ibis

- 10 Nov 2025
In News:
Recent sightings of a flock of Black-headed Ibis (Oriental White Ibis) in the salt pan regions of Thoothukudi district, Tamil Nadu, have drawn the attention of bird enthusiasts, ecologists, and conservationists. Such observations are significant not only for avifaunal studies but also as indicators of wetland health and ecological recovery, especially in coastal and human-modified landscapes.
About the Black-Headed Ibis
The Black-headed Ibis (Threskiornis melanocephalus), also known as the Oriental white ibis, Indian white ibis, or black-necked ibis, belongs to the family Threskiornithidae. It is a large wading bird, measuring about 65–76 cm in length, adapted to a wide variety of aquatic environments, which is why it is classified as a wader bird.
Morphologically, it is distinctive as the only native ibis species in its range with an overall white plumage combined with a black head and neck. Both males and females appear similar. Adults have greyish tail feathers, which turn jet black during the breeding season, adding to their ornamental appearance. The species is characterised by a long, curved bill, suited for probing mud and shallow water in search of food.
Habitat, Distribution and Ecology
The Black-headed Ibis is widely distributed across South and Southeast Asia, ranging from India westwards to Sri Lanka and eastwards up to Japan. It primarily inhabits wetlands, including lakes, marshes, riverbanks, and flooded agricultural fields. Notably, it is also found in coastal areas such as salt pans, as seen in Thoothukudi, and occasionally forages in dry fields and human-modified landscapes.
Its diet mainly consists of fish, insects, crustaceans, and other small aquatic organisms, making it an important component of wetland food webs. The presence of ibises, along with species such as flamingos, pelicans, and rosy starlings, reflects adequate food availability and suitable habitat conditions.
Conservation Status and Significance
At the global level, the Black-headed Ibis is classified as ‘Least Concern’ under the IUCN Red List. However, in parts of Asia, it is sometimes regarded as ‘Near Threatened’, owing to wetland degradation, pollution, altered hydrology, and habitat loss. This highlights the importance of regional conservation perspectives even when a species is not globally threatened.
The recent sightings in the salt pans of Thoothukudi are seen by experts as a positive ecological signal, suggesting improved habitat conditions following seasonal changes, particularly after the northeast monsoon (October–January), which replenishes wetlands and associated ecosystems.
Migratory Birds and Conservation Measures
The Thoothukudi observation also fits into a broader national context of avian conservation and migratory bird protection. Across India, wetlands and coastal regions act as crucial stopovers and wintering grounds for both resident and migratory birds. In this regard, proactive conservation measures, such as the declaration of a temporary ‘Silence Zone’ around Pangti village in Wokha district, Nagaland, to protect the globally significant congregation of Amur Falcons, demonstrate growing administrative and community awareness. Scientific studies have shown that excessive noise can disturb birds, disrupt breeding behaviour, and lead to habitat abandonment, underlining the need for habitat-sensitive governance.
INS Ikshak

- 10 Nov 2025
In News:
The commissioning of INS Ikshak marks a significant milestone in India’s maritime capability enhancement and defence indigenisation. As the third vessel of the Survey Vessel (Large) – SVL (Sandhayak) class, Ikshak represents a major boost to the Indian Navy’s hydrographic survey and charting infrastructure, which is critical for maritime safety, naval operations, and the blue economy.
Background and Commissioning
INS Ikshak is scheduled to be commissioned into the Indian Navy on 6 November 2025 at Naval Base, Kochi, in the presence of the Chief of Naval Staff, Admiral Dinesh K. Tripathi. Notably, it will be the first SVL-class ship to be based at the Southern Naval Command, enhancing hydrographic coverage in India’s southern maritime domain.
The vessel has been constructed by Garden Reach Shipbuilders and Engineers (GRSE) Ltd., Kolkata, one of India’s premier defence public sector shipyards. With over 80% indigenous content, Ikshak stands as a concrete outcome of the Aatmanirbhar Bharat initiative, achieved through close collaboration between GRSE and a large network of Indian Micro, Small and Medium Enterprises (MSMEs).
The name Ikshak, meaning “Guide” in Sanskrit, symbolically reflects the ship’s role in guiding safe navigation and charting uncharted or poorly mapped waters.
Design, Specifications and Capabilities
INS Ikshak is a technologically advanced hydrographic survey vessel designed for full-scale coastal and deep-water surveys of ports, harbours, and navigational channels. With a length of about 110 metres, a displacement of around 3,300 tonnes, and accommodation for over 230 personnel, the ship is built for long-duration and complex survey missions.
The vessel is equipped with state-of-the-art hydrographic and oceanographic systems, including:
- High-resolution multi-beam echo sounder and side-scan sonar for seabed mapping,
- Autonomous Underwater Vehicle (AUV) capable of operating up to 1,000 m depth with extended endurance,
- Remotely Operated Vehicle (ROV) for underwater inspection,
- Four Survey Motor Boats (SMBs) for shallow-water and near-shore surveys.
In addition, Ikshak features a helicopter deck, enhancing its operational reach for logistics, surveillance, and multi-domain missions. It is powered by diesel engines with an Integrated Platform Management System, bow and stern thrusters for precision manoeuvring, and a maximum speed of about 18 knots.
A unique feature of the SVL class is its dual-use capability. INS Ikshak can be converted into a 40-bed hospital ship, equipped with an operation theatre, laboratory, blood bank, and isolation wards, making it highly valuable for Humanitarian Assistance and Disaster Relief (HADR) operations.
Strategic and Economic Significance
The commissioning of INS Ikshak significantly strengthens India’s hydrographic excellence. Accurate hydrographic data and nautical charts are vital for:
- Safe navigation of commercial and naval vessels,
- Port and harbour development,
- Coastal security and naval planning,
- Seabed mapping for undersea cables, offshore energy, and marine resources.
The data generated by Ikshak will support the National Hydrographic Office and also contribute to India’s role as a regional hydrographic service provider, assisting friendly countries such as Mauritius, Sri Lanka, Bangladesh, and Myanmar.
From a strategic perspective, the ship enhances maritime domain awareness and underpins India’s ability to operate effectively across its vast maritime frontiers. From an economic standpoint, it supports the Blue Economy, facilitating sustainable use of ocean resources, port-led development, and marine infrastructure expansion.
